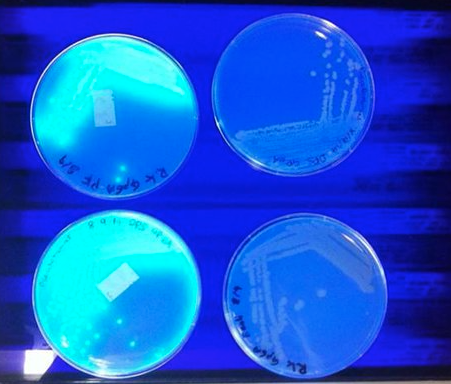

Understand how UV light harms bacteria. (Understand the mode of action of ultraviolet light on bacterial growth.)
UV light is part of the electromagnetic spectrum, but with shorter, higher energy wavelengths than visible light.
Prolonged exposure can be lethal to cells because when DNA absorbs UV radiation at 254 nm, the energy is used to form new covalent bonds between adjacent pyrimidines (cytosine-cytosine, cytosine-thymine, or thymine-thymine) called pyrimidine dimers
Differentiate UV-A, UV-B and UV-C and their effects on living cells
UV-A: the longest wavelengths, ranging from 315 nm to 400 nm
UV-B: wavelengths between 280 nm and 315 nm
UV-C: wavelengths ranging from 100 nm to 280 nm (these wavelengths -- more specifically, 240 nm-280 nm -- are most detrimental to bacteria; bacterial exposure to UV-C for more than a few minutes usually results in irreplaceable DNA damage and death of the organism
Understand the effects of UV irradiation on microorganisms that allow it to be used as for sterilization
the germicidal effect of UV-C is related to time of exposure, lamp intensity, and distance to the target; it also must have "line of sight" to the surface being decontaminated; that is, it does not penetrate well, bend around corners, or trickle into crevices
its effectiveness is diminished by dust, organic material etc. (UV-C as germicidal agent has its limitations)
Understand why UV irradiation has limited application for sterilizing materials
look at the previous card for answers to this
_________________________ mutations occur suddenly in nature under natural conditions; their origin is unknown; they are also called "background mutations"; they arise by the action of mutagenic agents present in the environment (these mutagenic agents include cosmic rays, radioactive compounds, heat and naturally occurring base analogues such as caffeine)
spontaneous mutations
_____________________ mutations can be artificially induced in living organisms by exposing them to abnormal environment such as radiations, physical conditions (e.g. temperature) and chemicals; the agents which induce artificial mutations are called mutagens or mutagenic agents
- these mutations are caused by mutagenic agents which are of two types..... physical agents: X-rays, UV-rays, α, β and γ-rays. chemical agents: Mustard gas, Ethylene amine, Colchicine, Ethyl-methyl sulphonate(EMS)
- it helps evolution and development of more genetic variations
induced mutations
Understand why some bacteria are less susceptible to UV irradiation than others. (For example: Understand why UV light is less successful at killing Bacillus spp. than Serratia marcescens)
Bacillus spp. forms spores which are less susceptible to UV irradiation
Define and describe photoreactivation
aka "light repair"
photoreactivation is when the repair enzyme, DNA photolyase, is activated by visible light (300-500 nm) and simply monomerizes the dimer by reversing the original reaction
this is a mechanism to repair UV DNA damage, used by E.coli
Define and describe excision repair (dark repair) of DNA
**look at pic too to help remember**
involves a number of enzymes:
the thymine dimer distorts the sugar-phosphate backbone of the strand; this is detected by an endonuclease (UvrABC) that breaks two bonds.
a helicase (UvrD) removes the 13-nucleotide fragment (including the dimer), leaving single-stranded DNA.
DNA polymerase I inserts the old DNA
which is then binded by DNA lygase and the repair is complete. E. coli
Interpret results of our experiment: How does UV irradiation affect Chromobacterium violaceum, Serratia marcescens and Bacillus subtilis var. niger? How does the ability to complete photoreactivation change those effects?
UV raditation affects all three but has the most affect on CV and Serratia because they are non-spore formers.
Completing photo reactivity by being put under the grow light, increased the amount of viable colonies. Grow light provides the energy for DNA photolyase.
Understand why a section of each experimental plate was not exposed to UV irradiation. (Understand why a portion of the plate remained covered with the cardboard.)
a portion remained uncovered as a control. In order for the results of the UV radation to be interpreted, there must be a control to compare them to.
the purpose of this exercise is to demonstrate the comparative effect of UV on two (or three) bacterial populations. This could have been accomplished without the cardboard cover. Why was the cover used?
to see how the control compared with the longest-exposed area on one plate with organism, then compare the plate as a whole to the other bacterial populations
the cover was used to show how there can be protection from the harmful UV rays of the sun
this is not a quantitative exercise. keeping this in mind can you see a general trend between bacterial death and UV exposure time?
more exposure results in more cell deaths
which organism survived the longest exposure? Why?
Bacillus survived the longest because it contains spores, which are resistant to heat
Why were you told to remove the plate covers prior to exposing them to UV?
The UV light has trouble penetrating the plate lid so organisms wouldn't have received much/any exposure when the lid is still on
consider the exposed part of the plate.
what does the relative sparseness of growth tell you about the effect of UV radiation?
UV radiation kills the bacteria
consider the exposed part of the plate.
what do individual colonies tell you about the cells from which they grew?
The cells were able to repair the damage caused by UV via light or dark repair
What does the relatively heavy growth on the plates covered by the mask and lid during exposure tell you about UV radiation?
UV radiation isnt strong enough to pass through card board
What is the effect of longer UV exposure on Serratia marcescens? Which plates should be compared?
Long UV exposure reduces/eliminates growth of the Serratia marcescenes. Plates with a mask and no lid exposed to UV for 3 seconds should be compared to plates that were exposed to 30 seconds.
What is the effect of the posterboard mask on UV radiation? Which plates should be examined?
The mask blocked UV radiation to the plates. Plates incubated in visible light should be compared to plates incubated in the dark. The areas covered by the mask showed growth, and the areas uncovered had very minimal growth.
What is the effect of the plastic lid on UV radiation? Which plates should be examined?
The plastic lid affected UV radiation from passing through. Plates with a mask and no lid should be compared to plates with a mask and a lid. The areas that were exposed to the UV light with plastic lid had growth.
what is defined media?
Totally made up of specific amounts of chemicals
Composed of inorganic salts and usually a carbon source such as
glucose
Example: Glucose Salts Agar, only organisms that
can make all their cellular components from glucose and inorganic
salts can grow on this medium
what is undefined media?
Contains such mixtures as extract or enzymatic digests of
protein
Sometimes called "rich medium"
Contain more preformed nutrients, and the organisms do not have
to use energy and materials to synthesize the compounds supplied in
the medium
Some bacteria can ONLY grow on this type of
medium because they cannot synthesize necessary components needed for
growth and must be provided with preformed amino acids, vitamins, and
other growth factors
Bacteria that require many growth
factors are termed "fastidious"
Example:
Trypticase soy agar (TSA), can support the growth of organisms that
require vitamins or other growth factors
what is a fastidious organism?
any organism that has a complex nutritional requirement; only grow when specific nutrients are included in the diet
a media which differentiates or distinguishes between different types of microorganisms based on differences in appearance of growth or color changes; the options for these tests are either/or (ex: either ferment lactose or do not ferment lactose)
example:
differential media
Starch hydrolysis (amylase test); they either hydrolyze starch or do not
this media that supports the growth of a variety of microbes
example:
all-purpose medium
Nutrient agar and tryptic soy agar
this media that contains dyes or toxics substances (chemicals) which inhibit the growth of certain microbes, but support the growth of others
selective media
this media allows the investigator to distinguish easily between the growth characteristic of various species
differential media
Explain why there is no universal medium capable of growing all bacteria
due to the differences in bacteria.. whether they're gram positive, gram negative, etc
there is NO such thing as a universal medium; any set of nutrients is capable of inhibiting some microorganisms while providing the growth of others
Name five all-purpose media
TSA (tryptic soy agar)
Blood agar
Nutrient
agar
Mueller-Hinton Agar
Brain heart infusion agar
Blood Agar is one of the media that is both _________________ and __________________
How?
all-purpose and differential;
it is a rich nutrient solution plus 5% to 10% animal blood; it supports the growth of a wide variety of microbes (this is the all-purpose part); it is differential because it produces different results if it has a hemolytic reaction or not
Observe and describe alpha, beta, and gamma hemolysis on Blood Agar
alpha: a greenish zone appears around the colonies; this means that there was incomplete lysis of RBCs
beta: there is clearing around the colonies and in the agar; this is a result of complete lysis of RBCs
gamma: appears as only growth and no change to the medium; this results from no hemolysis
Understand why, when streaking a blood agar plate, the medium was stabbed with the loop upon completion of the streaking
the stabs encourage streptolysin (hemolysins produced by streptococci) activity because of the reduced oxygen concentration of the subsurface environment
what are the two forms of streptolysins and what do they do?
Streptolysin O: oxygen labile and expresses maximal activity under anaerobic conditions
Streptolysin S: oxygen stable but expresses itself optimally under anaerobic conditions as well
Examine fluorescent and nonfluorescent pigments produced by Pseudomonas spp.
Pseudomonas Agar F enhances bacterial generation of _____________________ (fluorescent pigment that glows yellow-green) and inhibits formation of _______________________ (a blue-green nonfluorescent pigment). Pseudomonas Agar P has the opposite effects; (it controls production of these two pigments).
fluorescein
pyocyanin
how do you see the fluorescent pigment produced by Pseudomonas, which is not seen with only visible light?
employ ultraviolet radiation (UV light); the radiation excites electrons in the fluorescent pigment, to which the electrons glow and you can observe the light
Distinguish water soluble and nonsoluble bacterial pigments.
Water soluble pigments will diffuse through the agar; insoluble bacterial pigments will stay with the culture itself
just read this
Examine Pseudomonas Agar F (Flo Agar) under long wavelength UV light (366 nm) for fluorescin, a greenish-yellow fluorescent pigment in the colonies and surrounding medium. Examine Pseudomonas Agar P (Tech Agar) for pyocyanin, a blue to blue-green pigment seen in the colonies and surrounding medium. Confirm the presence of pyocyanin by adding several drops of chloroform and observe for a blue color in the chloroform. (Pyocyanin is more soluble in chloroform than in water.)
this is a digestive enzyme excreted from cells to then be phagocytized for nutrient absorption within the cell
exoenzyme
this is a non-digestive enzyme that functions within the cell; most enzymes fall under this category
endoenzyme
this means "to add water to break bond"
hydrolyze
Describe the value of exoenzymes to bacteria
Exoenzymes can breakdown macromolecules (ex: starch) into smaller molecules that then can be taken through the cell's membrane and be used as individual glucose molecules for metabolic value
what are the two extracellular enzymes that some organisms can produce to hydrolyze starch?
alpha-amylase
oligo-1, 6-glucosidase
suppose you had poured iodine on your plate and noticed clearings in the uninoculated area, as well as around both of your transferred cultures
a) what are some possible explanations for this occurrence?
starch was not mixed properly;
clearings suggest contamination
not seen before iodine was added;
test has been compromised and
needs to be redone
suppose you had poured iodine on your plate and noticed clearings in the uninoculated area, as well as around both of your transferred cultures
b) was integrity of the test compromised?
yes
suppose you had poured iodine on your plate and noticed clearings in the uninoculated area, as well as around both of your transferred cultures
c) what measures could be taken to avoid this problem in the future?
make sure there is no contamination before inoculating the organism; make sure starch was correctly mixed in the plate
how would you expect both positive and negative results to be affected if you were to add glucose to the medium?
the bacteria expected to eat starch will first use glucose since its easier to use as a substrate, so we won't be able to test for starch depletion using Iodine anymore because positive colonies may no longer test positive
a negative result could be caused if the organism utilized the glucose, but did not have he enzymes to hydrolyze the starch to use for glucose
the streak-stab technique, used to promote streptolycin activity, is preferred over incubating the plates anaerobically
a) why do you think this is so?
the stabs encourage streptolysin activity because of the reduced oxygen concentration of the subsurface environment; streptolysin still needs oxygen, just not as much as aerobic or anaerobic conditions provide
the streak-stab technique, used to promote streptomycin activity, is preferred over incubating the plates anaerobically
b) compare and contrast what you see as the advantages and disadvantages of each procedure
look at previous card answer
assuming that all of the organisms cultivated in this exercise came from the throats of healthy students, why is it important to cover and tape the plates?
because each student have their own unique flora which grow abundately when plated and incubated that are also opportunistic pathogens so it is important to take preventative measures
why is the streak plate preferred over the spot inoculations in this blood agar procedure?
quadrant streak is better for colony isolation as you start out with a much denser same and then isolate it down, making the test more reliable
define selective medium
this media that contains dyes or toxics substances (chemicals) which inhibit the growth of certain microbes, but support the growth of others
Demonstrate the advantages of a medium that is both selective and differential
both are used individually to narrow down possible identities of microbes, so both would narrow it down further, increasing the likelihood of properly identifying an unknown organism
How can Mannitol Salts Agar be classified as both selective and differential?
Mannitol provides the substrate for fermentation which makes it differential. Sodium chloride makes the medium selective because its concentration is high enough to dehydrate and kill most bacteria. Staphylocci thrive in this medium. Phenol red is the indicator. Used to isolate coliforms.
How can Eosin methylene blue plates be classified as both selective and differential?
Is selective for gram negative organisms because of the concentration of sugars and dyes. It is differential because acid produced by fermentation changes the color of dyes (pH indicator). The dyes are inhibitors and indicators
How can Columbia CNA be classified as both selective and differential?
Is selective beacuse antibiotics colistin and nalidixic acid (CNA) interfere with DNA replication and affect membrane integrity of gram negative oranisms. Is differential because of the blood which allows hemolysis to occur. Sheep's blood provides the X factor (heme) and yeast provides B vitamins
Explain why a colony on a selective medium is not considered pure
Selective media can still grow more than one species of bacteria
Summarize the appropriate procedure for obtaining a pure culture from the growth of an isolated colony on a selective medium
Remove several of what appears to be the same species using an inoculum loop. However, you cannot assume that there is only one species. Therefore, you must do another streak of the inoculum to better isolate pure colonies
this media encourages growth of some organisms and discourages growth of others
selective
this media allows us to distinguish between different microbes
differential
this media is "chemically defined"; each of its chemical ingredients is known and in exactly what amounts
defined
this media is "complex"; contains one or more ingredient made up of known ingredients, but of unknown composition
undefined
these are selected to obtain the optimum growth of the organisms being tested for or suspected of being in the sample
nutritional components
these are what make the medium selective; designed to exploit weaknesses in specific groups of organisms and thus prevent or inhibit their growth, while allowing other organisms to grow
inhibitors
these are what make the medium differential; differentiation and identification of organisms relies on their abilities to perform a specific chemical reaction or set of reactions in a way that can be observed
substrates
these make a desired or expected reaction visible; frequently a dye that is a pH indicator or chemicals that react with products to produce color change
indicators
Identify the nutritional components, inhibitors, substrates, and indicators in the three media we tested
yeah
What organisms are being selected for and against in each of the three media we tested
CNA: staphylococci, streptococci, enteroccocci are selected
for
Mannitol: Stahylococci spp.
EMB: coliforms such as E. coli
Distinguish the appearance of selected gram-negative bacterial colonies growing on EMB Agar, representing strong, moderate and non- lactose fermenters
Green on EMB agar plate: Acidic and vigorous fermenter
Purple:
Slightly acidic and moderate fermenter
No color change: Gram
negative, no fermentation
Distinguish the appearance of Staphylococci spp. on Mannitol Salt Agar
All Staphylococci grow but Staphylococcus aureus turns yellow to show mannitol fermentation
Why are bacteria, other than Staphylococci spp. unable to grow on Mannitol Salt Agar?
The sodium chloride concentration is too high. The salt causes most bacteria shrink and die
Understand the benefits and limitations of using the two antibiotics in Columbia CNA agar
It contains two antibiotics, colistin and naladixic acid, which inhibit the growth of gram-negative bacteria, thus selecting for Gram-positive organisms
what is specificity?
sensitivity?
specificity is making sure that everything is the same, otherwise a false positive could result
sensitivity is getting false negatives
Understand how the specificity and sensitivity of each medium can be changed
okay
in your own words, what is the application (purpose) of Columbia CNA with 5% sheep blood agar?
is a differential, undefined, selective media that allows growth of gram positive organisms and stops or inhibits growth of most gram negative organisms
which ingredient(s) in Columbia CNA plus 5% sheep blood agar supply(ies)
a) carbon
casein, digest of animal tissue, beef extract, yeast extract, corn starch, and sheep blood
which ingredient(s) in Columbia CNA plus 5% sheep blood agar supply(ies)
a) nitrogen
beef extract and peptones
is Columbia CNA agar a defined or an undefined medium? Provide the reasoning behind your choice and explain why this formulation is desirable.
it is an undefined, differential, and selective medium that allows growth of Gram-positive organisms (especially staphylococci, streptococci, and enterococci) and stops or inhibits most Gram-negative organisms
in your own words, what are the roles of colistin and nalidixic acid in CNA and how does each work?
colistin and nalidixic acid are antibiotics that act as selective agents AGAINST Gram negative organisms
C = colistin contains many polycationic regions that can insert into the outer membrane of the Gram negative bacterial cell wall the insertion of colistin into the outer membrane disrupts the integrity of the outer membrane, which can lead to bacterial lysis
NA = nalidixic acid inhibits DNA gyrase/topoisomerase
DNA
gyrase/topoisomerase allows supercoiled DNA to be relaxed and reformed
and is necessary for DNA replication. Therefore, nalidixic acid
inhibits DNA synthesis Gram negative bacteria are more sensitive to
nalidixic acid than Gram positive bacteria
what is the role of sheep blood in CNA agar?
sheep blood makes possible differentiation of Gram-positive organisms based on hemolytic reaction
growth on the Columbia CNA and NA plates was recorded as "good growth," "poor growth," or "no growth." These are qualitative and, at least for the first two subjective terms. What did you use to establish what constituted "good growth?"
good growth: had growth plus clearing of medium; organism is not inhibited by colistin and nalidixic acid and completely hemolyzes RBCs; beta hemolysis (beta is best)
poor growth or no growth: organism is inhibited by colistin and nalidixic acid; probably Gram-negative organism
good growth with greening of medium: organism is not inhibited by colistin and naldixic acid and partially hemolysis RBCs; alpha hemolysis
good growth with no change of medium's color; organism is not inhibited by colistin and naldixic acid and does not hemolyze RBCs; gamma hemolysis
why wouldn't it be advisable to compare growth of the organisms on each plate to each other? there are at least two answers to this question.
You do not know how the inhibitors may have affected the growth of the different organisms. So you can't compare growth on selective media. Even on TSA the growth of different organisms is likely different. One may grow really well and one less well (thinner growth). You might also inadvertently add different amounts of organism, but hopefully you are getting more consistent.
would removing colistin and naldixic acid from CNA alter the media's sensitivity or specificity?
specificity... why?
why might colistin affect Gram-negative bacteria more severely than Gram-postive bacteria? (hint: consider their structural differences)
cCNA affects the membrane. Gram positive have a thicker peptidoglycan wall
compare the recipes of nutrient agar and Columbia CNA agar. If an organism can grow on both media, on which would you expect it grow better? explain your answer.
I donut know
in your own words, what is the application (purpose) of MSA?
used for the isolation and differentiation of Staphylococcus aureus from other Staphylococcus species
which ingredient(s) in MSA supply(ies)
a) carbon
b) nitrogen
carbon: proteins/beef extract and peptone
nitrogen: beef extract
and peptone
is MSA agar a defined or an undefined medium? Provide the reasoning behind your choice and explain why this formulation is desirable
There are defined media. Be sure to know the difference. I think all we used were undefined. What makes a medium undefined is the presence of an ingredient that is itself a mix of nutrients, growth factors and the like. As Jane says, from one batch to another the amounts within those ingredients will change. They are really asking you to identify the undefined ingredients.
what is the role of sodium chloride in MSA and how does it work?
sodium chloride makes the medium selective because its high concentration to dehydrate and kill most bacteria
what is the main function of mannitol in MSA?
mannitol provides the substrate for fermentation and makes the medium differiential
what is the function of phenol red in MSA?
phenol red indicates whether fermentation has taken place by changing colors as the pH changes
growth on the MSA and NA plates was recorded as "good growth," "poor growth," or "no growth." These are qualitative and, at least for the first two subjective terms. What did you use to establish what constituted "good growth?"
good growth: organism is not inhibited by NaCl (Staphylococcus)
poor growth: organism is inhibited by NaCl (not Staphylococcus)
yellow growth or halo: organism produces acid from mannitol fermentation (possible pathogenic Staphylococcus aureus)
organism does not ferment mannitol: (Staphylococcus other than S.aureus)
would removal of sodium chloride from MSA alter the medium's sensitivity or specificity? Explain your answer.
It would alter the medium's specificity because you could not select for the Staphylococcus
Suppose a mistake is made in preparing a batch of MSA and the stating pH is 7.4 instead of 7.0-7.2. Would that affect the medium’s sensitivity or specificity? Explain.
Sensitivity is getting false negatives. We are looking for a color change due to acid production. If you start at a higher pH, more alkaline, then it will take longer (more acid) to change the color.
with the diversity of microorganisms in the world, how can a single test such as MSA be used to "confidently" identify Staphylococcus aureus?
With the diversity of microorganisms in the world, how can a single
test such as MSA be used to confidently identify staphylococcus
aures?Salt levels in MSA inhibit all Gram (-) leaving gram (+)
cells.
Only staph species can tolerate high salt, eliminating all
other gram (+) microbes
Only S. Aures can ferminent mannitol, eliminating all other
staph species.
what is the application (purpose) of EMB agar?
it is a complex (chemically undefined), selective, and differential medium; EMB agar is used for the isolation of fecal cloakrooms; it can be streaked for isolation
which ingredient(s) in EMB agar supplies
a) carbon
b) nitrogen
carbon is provided by the gelatin
nitrogen is also provided by the gelatin
what are the roles of eosin Y and methylene blue in EMB agar?
they inhibit the growth of Gram-Positive organisms and react with vigorous lactose fermenters and turn growth dark purple to black
what is the role of lactose in EMB agar?
it supports coliforms such as Escherichia coli
this is usually accompanied by a green metallic sheen (it ferments lactose a butt ton, in other words)
growth on the EMB and NA plates was recorded as "good growth," "poor growth," or "no growth." These are qualitative and, at least for the first two subjective terms. What did you use to establish what constituted "good growth?"
good growth: organism is not inhibited by eosin and methylene blue (Gram neg)
growth is pink and mucoid: organism ferments lactose with little acid production (possible coliform)
growth is "dark" (purple to black with or without green metallic sheen): organism ferments lactose and/or sucrose with acid production (probable coliform)
growth is "colorless" (not red or pink): organism does not ferment lactose or sucrose (noncoliform)
would removing eosin Y and/or methylene blue from EMB agar alter the medium's sensitivity or specificity? explain.
I don't know, do you?
Suppose a mistake is made in preparing a batch of EMB and the stating pH is 7.6 instead of 6.9-7.3. Would that affect the medium’s sensitivity or specificity? Explain.
Sensitivity is getting false negatives. We are looking for a color change due to acid production from lactose fermentation. If you start at a higher pH, more alkaline, then it will take longer (more acid) to change the color.
Understand the necessity of performing a Gram stain and an oxidase test in conjunction with API20e testing. (The reasons are different.)
Must confirm that organism is a gram-negative rod
Perform the API20e study on an unknown organism. Know how to read the strip (with the information sheet) and determine the 7 or 9 digit code. Use the code to identify the organism.
okay
Understand the purpose of adding mineral oil to certain tubes in the API20e test strip; understand why some of the media are filled so that both the tube and cupule is full
The mineral oil creates an anaerobic environment. Some tubes are filled because these organisms require oxygen.
Understand the purpose of adding deionized water to the incubation chamber of the API20e test strip.
To keep the test from drying out by keeping the chamber moist (humidified)
Understand when and why it would be appropriate to extend the test and use a 9 digit code for identification. (This and the next objective are related.)
If the oxidase test is positive and if 7 digit code is not discriminatory enough after all reagents have been added
Understand the two sets of procedures for continuing the API20e test after the initial incubation period. What defines which set of procedures will be followed?
Oxidation-Fermentation Test
Motility Test
Understand the various time limitations of this test. (Incubation time and reading reactions with reagents, for example.)
the results, especially colors, can vary depending on the amount of time the test has been incubated
Prepare samples and interpret the results of Motility Test Medium.
okay
Understand why tetrazolium salt is added to some preparations of Motility Test Medium
it is sometimes added to the medium to make interpretation easier (an indicator); TTC is used by the bacteria as an electron acceptor.. when oxidized- colorless and soluble, when reduced- red and insoluble
Understand why the amount of agar in Motility Test medium is set to 0.4%.
to allow for the movement of motile bacteria
Prepare samples and interpret the results of O-F Medium to test the oxidative/fermentative abilities of organisms.
Sealed: green or blue = oxidation
Unsealed: any yellow =
oxidation
Both: yellow throughout = oxidation and fermentation,
slightly yellow at top = slow fermentation, green or blue = no fermentation
Tubes that are (1) sealed and (2) unsealed and show yellow throughout
1. oxidation and fermentation
2. fermentation only
Tubes sealed: show green
Tubes unsealed: show yellow on top/
green on bottom
Oxidation only
Sealed: yellow on top/ green bottom
Unsealed: yellow on top/
green bottom
Slow fermenters
Tubes that show blue or show no change in color
are not able to metabolize sugars
Understand why O-F medium contains a high sugar to peptone ratio. (Relate this to Phenol Red Broth.)
to reduce the possibility that alkaline products from peptone utilization will neutralize weak acids produced by the oxidation of the carbohydrate
Understand why one tube of O-F medium is layered with sterile mineral oil and another left unsealed for each organism tested
To test organism each in an aerobic and anaerobic environment
what is the purpose of the oxidation-fermentation test?
it is designed to differentiate bacteria on the basis of fermentative or oxidative metabolism of carbohydrates
oxidative organisms oxidize the carbohydrate to ____________ and ___________, and ____________
CO2, H2O and energy
Prepare samples and interpret results of the selective/differential medium MacConkey Agar/ what is the purpose of the MacConkey Agar?
it is used to isolate and differentiate members of the Enterobacteriaceae based on the ability to ferment lactose
Understand the selective and differential aspects of MacConkey Agar.
bile salts and crystal violet make it selective (inhibit Gram-positive bacteria).
neutral red makes it differential. lactose fermentation builds up acid, turning the fermenters red. Used to differentiate Enterobacteriacaea.
How is MacConkey Agar modified to allow the study of Enterococcus spp. and Staphylococcus spp.?
By not adding crystal violet. The colonies ferment lactose and appear pink.
List other multi-test media that we have used and what these test for and what organisms they are designed to differentiate.
okay
What is the complete definition of a coliform?
What defines the family Enterobacteriaceae?
a coliform is a Gram-negative, non spore forming rod that can ferment lactose; is a member of the Enterobacteriaceae
a family of gram-negative, facultatively anaerobic, rod-shaped bacteria, usually motile; found in soil, water, and plants and in animals from insects to humans; Escherichia, Klebsiella, Enterobacter, Proteus,Providencia, and Serratia
what is the application (purpose) of the MacConkey agar?
used to isolate and differentiate members of the Enterobacteriaceae based on the ability to ferment lactose
which ingredient(s) in MacConkey agar supply(ies)
a) carbon
b) nitrogen
a) lactose: fermentable carbohydrate providing carbon
b) casein and animal tissue: provides nitrogen
what are the roles of crystal violet and bile salts in MacConkey agar?
Bile salts and crystal violet inhibit the growth of Gram positive organisms
what are the roles of neutral red and lactose in MacConkey agar?
- Lactose provides the sugar substrate for fermentation
- Neutral red dye is a pH indicator which turns red when acidic and is colorless when basic, which indicates the fermenters from non fermenters
growth on the MacConkey agar plates was recorded as "good growth," "poor growth," or "no growth." These are qualitative and, at least for the first two subjective terms. What did you use to establish what constituted "good growth?"
good growth: organism is not inhibited by crystal violet or bile (Gram negative)
poor growth or no growth: organism is inhibited by crystal violet and/or bile (Gram positive)
pink to red growth with or without bile precipitate: organism produces acid from lactose fermentation (probably coliform)
growth is "colorless" (not red or pink): organism does not ferment lactose (noncoliform)
would removing bile salts and/or crystal violet from MacConkey agar alter the medium's sensitivity or specificity? Explain.
Removing makes it no longer selective and reduces specificity; allows growth of gram positive
Nutrient Agar vs MacConkey
Would grow faster on Nutrient Agar -- it contains both beef extract and peptone. Organism does not have to overcome nutrient sources
consider the controls of the oxidase-fermentation test:
a) what is the purpose of the uninoculated control tubes used in this test?
Two uninoculated control tubes are needed to show the results of the medium in both aerobic and anaerobic environments. It is used to show that the medium remains green under both conditions, showing it is sterile and also as a color comparison
consider the controls of the oxidase-fermentation test:
b) are the controls positive or negative controls? Explain.
negative.. a positive result would either turn the media yellow, indicating fermentation and an acidic environment, or it would turn blue, indicating deamination and an alkaline environment
consider the controls of the oxidase-fermentation test:
c) why is it necessary to use two controls rather than just one? what are the specific purposes of each?
one of the controls exhibits an anaerobic environment, and the other an aerobic environment
some microbiologists recommend inoculating a pair of OF basal media (without carbohydrate) along with the carbohydrate media. Why do you think this is done?
Basal media (without carbs) allows you to see what the organism does with medium without the presence of the carbohydrate. Allows you to have an "active" negative control.
all enterics (Enterobacteriaceae) are facultative anaerobes; that is, they have both respiratory and fermentative enzymes. What color results would you expect for organism in O-F glucose media inoculated with an enteric? Remember to describe both sealed and unsealed tubes.
Enteric bacteria are facultative anaerobes, meaning they are capable of both aerobic and fermentative metabolism. What results would you expect to see in both sealed and unsealed OF tubes with such a bacterium?
Suppose that when you examined your tubes after incubating them, you noticed that the unsealed control contained slight yellow at the top. Suppose further that pair 1 showed complete yellow of both tubes and pairs 2 and 3 showed slight yellowing of the unsealed tube. Assuming all other tubes were green, what conclusions could you safely make?
Which results, if any, are reliable? Why
Which results, if any, are unreliable? Why not?
Probably the inoculations made according to the directions in the procedure contained in the lab book. The procedure calls for three organisms to be inoculated. The slight yellowing in the unsealed control tube suggests there might be a contaminant (aerobic) in the media. This would make the slight change in the sets 2 and 3 questionable and probably the tests should be done again. Pair 1 shows that the organism is fermentative and possibly oxidative, due to the complete yellowing of both tubes. We found that the oxidative only organisms tended to show much more than "slight" yellowing, so having the control suggests that pairs 2 and 3 are negative, from our experience.
Uninoculated tubes and tubes inoculated with an organism that is (N) serve as negative controls. What information is provided by each?
These are two forms of negative control. A third would be the use of basal media (no carb media). The uninoculated control tells us what the media does when it is incubated. Does the color change? Gas bubble formation? The inoculation of a non-saccharolytic organism (coded N) would be the effect of incubation of an organism that is unable to use the sugar either oxidatively or fermentatively. This might not grow at all or may use the peptones and form alkaline products.
for the motility test, why is it important to carefully insert and remove the needle along the same stab line?
lateral movement of the needle will make interpretation more difficult
consider the TTC indicator
a) why is it essential that the reduced TTC be insoluble?
b) why is there less concern about the solubility of the oxidized form of TTC?
TTC is used as a redox indicator and is soluble in water
why is it important to perform the reagent tests last in the API20E test?
Because you need to look for spontaneous reactions first. Also, if you splash reagents into adjacent cups you could change their color
what is a spontaneous reaction?
a reaction that does not require an addition of reagent(s)
in clinical applications of this test system, reagents are added only if the glucose (oxidation/ fermentation) test result is yellow or at least three other test are positive. If these conditions are not met, a MacConkey agar plate is streaked and additional tests are performed confirming glucose metabolism, nitrate reduction, and motility. Why do you think this is so? Be specific.
do not know
suppose after 24 hours incubation, you notice no growth in the tubes containing mineral oil. Assuming that it is behaving properly under these conditions, what do you know about the organism and what predictions can you safely make about its performance in the decarboxylase tests, fermentation tests, and nitrate reduction tests? Is it a member of Enterbacteriaceae?
no, because Enterbacteriaceae are facultative anaerobes; therefore, it could behave under anaerobic conditions
characteristics of Enterobacteriaceae
